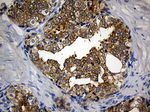
CIB1 Antibody in Immunohistochemistry (Paraffin) (IHC (P))
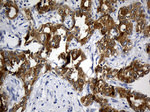
CIB1 Antibody in Immunohistochemistry (Paraffin) (IHC (P))

Search
OriGene
CIB1 Monoclonal Antibody (OTI1B8), TrueMAB™
{{$productOrderCtrl.translations['antibody.pdp.commerceCard.promotion.promotions']}}
{{$productOrderCtrl.translations['antibody.pdp.commerceCard.promotion.viewpromo']}}
{{$productOrderCtrl.translations['antibody.pdp.commerceCard.promotion.promocode']}}: {{promo.promoCode}} {{promo.promoTitle}} {{promo.promoDescription}}. {{$productOrderCtrl.translations['antibody.pdp.commerceCard.promotion.learnmore']}}
产品信息
TA811147
种属反应
宿主/亚型
分类
类型
克隆号
抗原
偶联物
形式
浓度
规格
纯化类型
保存液
内含物
保存条件
运输条件
靶标信息
The protein encoded by this gene is a member of the calcium-binding protein family. The specific function of this protein has not yet been determined; however this protein is known to interact with DNA-dependent protein kinase and may play a role in kinase-phosphatase regulation of DNA end joining. This protein also interacts with integrin alphabeta, which may implicate this protein as a regulatory molecule for alphabeta.
仅用于科研。不用于诊断过程。未经明确授权不得转售。
篇参考文献 (0)
生物信息学
蛋白别名: calcium and integrin binding 1 (calmyrin); Calcium and integrin-binding protein 1; Calcium- and integrin-binding protein; calcium-binding protein family member; CIB1; Calmyrin; CIB; CIB1; CIBP; DNA-dependent protein kinase interacting protein; DNA-PK interaction protein; DNA-PKcs-interacting protein; Kinase-interacting protein; KIP; SIP2-28; SNK-interacting protein 2-28; testicular secretory protein Li 9
基因别名: CIB; CIB1; CIBP; EV3; KIP; KIP1; PRKDCIP; SIP2-28
UniProt ID: (Human) Q99828
Entrez Gene ID: (Human) 10519